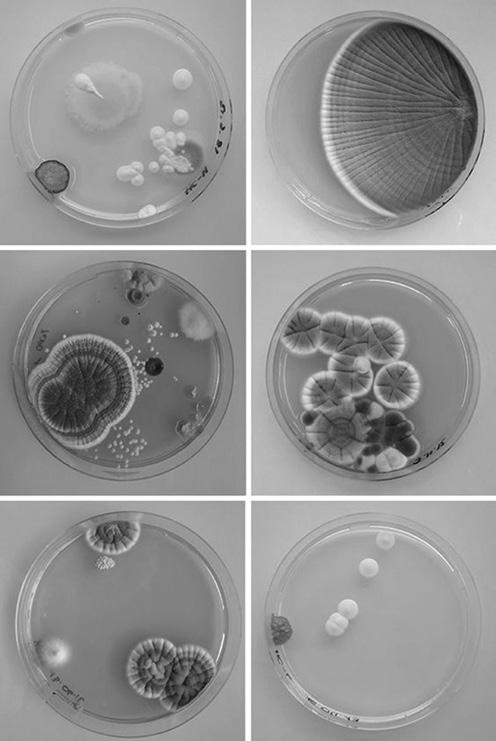

JOS PRIJS BRINK 2023



Thank you for your commitment to improving the position of lesbian women, gay men, bisexual men and women, transgender people and intersex people in society. This book is a collective work of students, alumni, and teachers from the Royal Academy of Art, the Hague who wanted to express their gratitude for the winner. Your work has not only made a change in society and contributed to the acceptance of the LGBTQ+ community, but has also inspired a new generation of designers to work together and look at design as a social responsibility. We all thank you for your work and effort.
Read this book as further inspiration to continue the work and be proud of the positive changes you have created. You are a role model for many of us.


My concept explores the moments of reflection and strength required when questioning the things around us. These moments are crucial for moving forward as a society. With my research I wish to express my admiration towards the LGBTQ+ community as they challenge and help to expand the outdated societal norms that no longer serve us. With their strength and courage at the forefront, new possibilities open up, which allow everyone to free themselves of expectations and reach their truest most authentic selves.





I felt very honored while working on this emancipation award. It brought me joy and a sense of determination as I wish to contribute the best I can.
Why shouldwebe tiedto the restraintsof society and limit ourselvesto one wayof seeing the world?





I want this award to feel like a source of strength and inspiration. I hope that the receiver of this award will feel appreciated for all the work they have done.











I wantto remindthe winnerthatby breaking down stereotypes,weare openingup new perspectives, and overcomingthe imposed patternsof society.
In my concept, I wanted to materialize the struggles of the community. I’ve created a metal frame to represent the imposed patterns of society and integrated a fluid material to show the possibility of stretching those restrictive boundaries. We are often born in cages, but we shouldn’t limit ourselves to them. Instead, we should find the courage to break out.




My trophy and brooch are the struggles of the LGBTQ+ community materalized in volume. I created a frame that represents the imposed patterns of society. Inside the frame there is a form, which represents the LGBTQ+ community, or any person, who wants to escape from these constraints. This form which tries to fit the rules, ends up overflowing the cage which was not designed for it.

I want to remind society that one’s sexuality does not define them, and should not be the cause of rejection. The battles that the LGBTQ+ community fight are particularly important in defending each person’s ability to choose who they are. The visibility of these battles allows young people to identify with other people who are like them.


As for the winner, I want them to know that for my brooch I took inspiration from the movement of water escaping. This movement is erratic, out of human control and has no gender. For me, that is the true definition of freedom.






This trophy symbolizes the process of unraveling and expanding the authentic self, which someone as part of the LGBTQI+ community can have a hard time with, due to numerous factors. It shows what effect bravery in doing so has. The frame breaks open and there are endless possibilities to expand. Because of the strength, limitation is no longer possible, and any attempt to limit will roll right off.





One of the goals I have while creating something is to tell a story, especially when that story represents values I stand for in life. I felt very honored to be a part of this because the topic of emancipation has accompanied me throughout my life, this time in a professional creative way.





I hope the winner will see this as a symbol of the work they have done, since they are the one helping others break open their cages.
Embraceindividualityinsteadoffightingitbecausewealldeservetobeauthentic.







With my concept, I wanted to create a reminder of the ongoing fight for social safety. No matter who we are, who we love, or how we identify, we all have the right to equal treatment. It is an ode to the winner, showing my appreciation for a person who provides a sense of hope for equality. While developing my work I was aiming to highlight the transitions and challenges that occur when we blossom into our true identities without fear of judgment. My material choice is reflective of an item commonly used to protect wounds and help heal them: the plaster bandage.





I wouldliketothankthewinnerforsupportingthequeercommunity— yourconstanteffortisseenandappreciated.
asDevelopingmyconceptputmeinauniquepositiontomakeastatement adesigner.Weshouldn’tforgetthatnotlongago,beingyourselfmeant breakingthelaw.











I want the winner to feel excited. It is a moment of celebration for all of their contributions to society.




My concept is about being connected, which comes with natural urges to embrace and protect. Throughout history, the LGBTQ+ community has faced discrimination and violence. Community members often protect each other, and act as shields for one another. Behind those defensive shields are feelings of pride, embrace and comfort. I wanted to represent both sides: the sharp pieces of my object not only portray the defensive system, but also serve as a proud crown piece with a combined steel shell to depict those feelings of protection and comfort.





Asadesigner,I am interestedinsocial behavior andsocietyatlarge.The opportunityto makea positive contributiontothe LGBTQ+ community mademefeelreally honored.


I hope my piece will remind the winner that they are the connection that provides protection and empowerment to the community.

Day after day we do the same tasks, think the same things, and act the same way. We get stuck in a behavioral autopilot where we are unwilling to change or reflect on what we believe in. The LGBTQ+ community has been restrained and labeled by society based on centuries-old constructs. Breaking free of these social constructs and urging society to change their views will enable us to grow. In society, everyone is privileged in one way or another. If people started to accept the privileges they have and use them to help others, society would be able to grow and evolve. This is what my design symbolizes. The grey element represents current social constructs and the organic felt structure shows the freed and evolved version of society that we seek.





I felt very honored to be designing for such an important cause. As an upcoming designer, handing over my work to someone who has improved the lives of so many LGBTQ+ people, is a great privilege.





I hope the winner feels proud and empowered while wearing my piece. I hope my piece serves as a reminder of the impact they made on so many, and motivates them to continue breaking down the barriers the LGBTQ+ community faces daily.
Don’tbeafraidtoquestionyourbeliefsbecause thatisthefirststeptocreatingchange.








In recent decades, the LGBTQ+ community has seen an outstanding increase in recognition. Still, there is so much work to be done in amending our societies to fit them. While that is often discussed, I believe its important to cherish the fact that nowadays the LGBTQ+ community is more united than ever, and can reach each other more easily (due to social media). This means that individuals who may have felt isolated in the past can now organize more efficiently, communicate more effectively and help each other out.


I know from personal experience how crushing it feels to be isolated due to your differences. I truly understand how much that hurts.


collectively has made over the years towards a more inclusive and accepting society, and


I hope the person who receives this award can feel proud of the progress that everyone
increased unity within the LGBTQ+ community.
I felt that participating in this project was something important, both for my growth as a designer and for this meaningful cause.

Although you may feel alone at times, know that there are plenty of people similar to you, even if you don’t know their stories. You only need to reach out.








Within my concept, I explore the communication channels between societal minorities and majorities. Without dialogue, a healthy society cannot exist. While starting conversations comes with complications, keeping such discussions going is the only way to reach a common ground and understanding. It is important to celebrate and remember every small achievement, as these celebratory moments give us the energy to move on to the next challenges.




Working for the emancipation award meant responsibility to me as a designer; a responsibility to communicate a very important message from my creative point of view.





I hope that while wearing my piece the winner feels the importance of being heard, and is never afraid to start a conversation.

Addressing change is uncomfortable but we should all encourage one another to do so.






Kes Lugt is currently enrolled in the fine arts department at the Royal Academy of Art, The Hague. Departing from personal experiences of non-binary-genderedness, Kes Lugt’s multifaceted practice revolves around embodied manifestations in a contemporary (electronic and bureaucratic) world. By using the playful and humourous as making strategies — placing a bouncy castle inside of a gallery for example — Kes demonstrates the joy and feelings of release that can arise.
With the execution of the silver brooch for the emancipation awards from the Ministry of Culture, Education and Science, Kes’ contribution to the cause shows the perspective of an artist who is engaging in several societal and cultural concepts within the field of art, while broadening the sense of liberation through different forms and ideas.
Guido van der Linden is an artist and designer. Alongside his own practice, he is a workshop instructor and tutor at the Royal Academy of Art, the Hague (KABK). After graduating from the fine arts department, Guido established his own studio where he creates autonomous sculptures and designs for both exhibitions and private collections.
Guido van der Linden designed the boxes for the winners of the emancipation awards. Although his task was to create something to support the brooches, he focused heavily on constructing the boxes, carefully selecting the wood and emphasizing how the purity of wood joints and the material itself can serve as the framework for the brooches. Being part of the team who worked on the design for the OCW awards was a great motivator. As a tutor he finds it important to create environments in which people can grow and thrive, which are often difficult to find in our society. Equality and acceptance are important practices in creating an environment where everyone is valued. Striving for inclusion without losing one’s own values is memorable and should be awarded.
Lara Dautun is a graphic designer focused on editorial practices. Currently researching feminist independent publishing, she strives to uncover the emancipatory potentials of such practices and the role design tools can play in the process. Working on this book has been a joy for her, as it has allowed her to build on her personal research and connect with themes, stories, and ideas that inspire her. Through the book’s design, Lara hopes to showcase the collaborative and fluid nature of the creative process, as well as highlight the unique perspectives and ideas of the students involved.
The Jos Brinkprijs 2023 was designed by the firstyear students of the Interior Architecture and Furniture Design department at the Royal Academy of Art, The Hague (KABK) in collaboration with the Ministry of Education, Culture and Science (OCW).

Alexandria Liiv
Anna Simeone
Aylin Sanci
Emily Vassallo Medici
Femke Huberts
Ponke Mühlig
Rares Chereji Nicolae
Saulė Andrejevaitė
Ellen Maria Vos, Zsofia Kollar
Mariska Beljon
Guido van der Linden
Kes Lugt
PHOTOS
Medina Rešić
Sidney Nislow
Lara Dautun
Printed by Raddraaier, Amsterdam on Rebello 120grs
Binded by Agia, Amsterdam
6 copies.
TYPOGRAPHY
Adelphe, by Eugénie Bidaut, available on Bye Bye Binary’s typotheque.
(https://typotheque.genderfluid.space)
G.B. Jones, by Nat Pyper, part of the great project A Queer Year of Love Letters.
(www.librarystack.org/a-queer-year-of-love-letters/)
This book is a result of an educational project in collaboration with the Ministry of Education, Culture and Science and the Royal Academy of Art, The Hague. This book is a result of a research project with no commercial purpose.